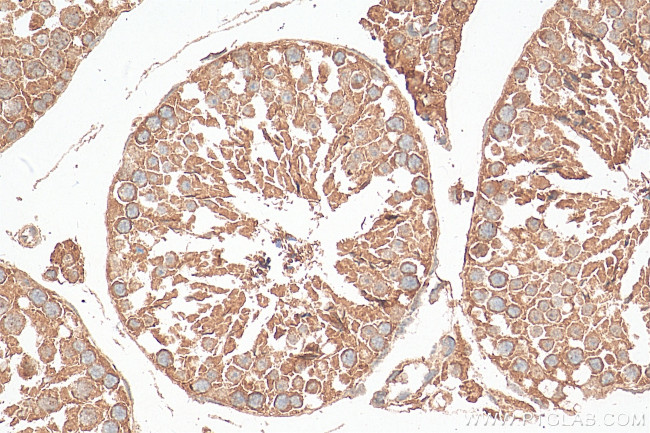
RALGAPA2 Antibody in Immunohistochemistry (Paraffin) (IHC (P))

Search
Proteintech
RALGAPA2 Polyclonal Antibody
{{$productOrderCtrl.translations['antibody.pdp.commerceCard.promotion.promotions']}}
{{$productOrderCtrl.translations['antibody.pdp.commerceCard.promotion.viewpromo']}}
{{$productOrderCtrl.translations['antibody.pdp.commerceCard.promotion.promocode']}}: {{promo.promoCode}} {{promo.promoTitle}} {{promo.promoDescription}}. {{$productOrderCtrl.translations['antibody.pdp.commerceCard.promotion.learnmore']}}


Please note: We are reviewing Western blot images included in the antibody testing data in our catalog, including those provided by third parties. Unless expressly labeled or annotated as “raw-unedited”, Western blot images included in the antibody testing data in our catalog may have been edited, optimized or otherwise adjusted for presentation.
Product Details
29843-1-AP
Species Reactivity
Host/Isotype
Class
Type
Immunogen
Conjugate
Form
Purification
Storage buffer
Contains
Storage conditions
Shipping conditions
Product Specific Information
Immunogen sequence: YSWDGKVLYG PLEGCLAPNG RNPSFLISSW HRDTFGPQKD SSQVEEGDDV LDKLLENIGH TSPECLLPSQ LNLNEPSLTP CGMNYDQEKE IIEVILRQNA QEDEYIQSHN FDSAMKVTSQ GQPSPVEPRG PFYFCRLLLD D
Target Information
Catalytic subunit of the heterodimeric RalGAP2 complex which acts as a GTPase activator for the Ras-like small GTPases RALA and RALB.
For Research Use Only. Not for use in diagnostic procedures. Not for resale without express authorization.
References (0)
Bioinformatics
Protein Aliases: 250 kDa substrate of Akt; AS250; P220; ral GTPase-activating protein alpha subunit 2; Ral GTPase-activating protein subunit alpha-2
Gene Aliases: A230067G21Rik; AS250; BC053994; C20orf74; KIAA1272; pp250; RALGAPA2; RGC2
UniProt ID: (Mouse) A3KGS3
Entrez Gene ID: (Mouse) 241694

Performance Guarantee
If an Invitrogen™ antibody doesn't perform as described on our website or datasheet,we'll replace the product at no cost to you, or provide you with a credit for a future purchase.*
Learn more
We're here to help
Get expert recommendations for common problems or connect directly with an on staff expert for technical assistance related to applications, equipment and general product use.
Contact tech support